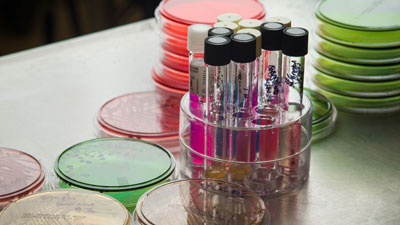

Biological Sciences B.S. or B.A.
Explore the biological sciences bachelor’s degree program at the University of Alaska Anchorage
The University of Alaska Anchorage’s Bachelor of Science and Bachelor of Arts in biological sciences degree programs combine concepts in biology — the study of living organisms — with core coursework in chemical, physical and mathematical sciences.Biological sciences scholarships and financial aid
A variety of scholarships and financial aid resources are available through the UAA Office of Financial Aid. Learn more about financial aid opportunities at UAA.
Traditional and modern topics
Explore a variety of topics in biology, including plants and wildlife, physiology and toxicology, microbes, molecular biology, genetics and human health.
Practical job skills
Learn and apply concepts in biology to develop scientific reasoning, critical-thinking and communication skills that will help you get into graduate school or qualify for a variety of employment opportunities after graduation.
Arctic studies
Question, research and discuss topics unique to the region’s environment and population, from the lucrative field of bioinformatics to UAA’s developing program in microbiology, including pathogenic microbiology and biochemistry.
Academic advising in biology
Planning your future may seem daunting, but dedicated academic advisors in biological sciences can help take the stress out of it. With their guidance, you can choose classes that best fit your personal interests, degree program requirements and career goals.
Biology student clubs and professional organizations
Join the student chapter of a professional organization related to your field, such as the American Medical Student Association, American Academy of Developmental Medicine and Dentistry and American Indian Science & Engineering Society. You can also choose from 100 student clubs on campus, including Medical Laboratory Science and Pre-Pharmacy.
What can you do with a biology degree from UAA?
The Bachelor of Arts and Bachelor of Science undergraduate programs in biological sciences prepare you for entry-level jobs in biology and help you qualify for graduate school.Biological sciences graduate programs
Continue your education and earn a research-based M.S. or Ph.D. degree, or a professional degree in medicine, law or teaching. The University of Alaska Anchorage offers a M.S. in biological sciences graduate program to supplement your bachelor’s degree in biological sciences. You can also pursue a Ph.D. in biological sciences at the University of Alaska Fairbanks with a UAA faculty member as your advisor.
Biological sciences careers
Jobs with a biology degree range from government to academia to industry.
- Biologist
- Biochemist
- Biophysicist
- Microbiologist
Biological sciences bachelor’s degree program highlights
Take control of your future and choose your own path to success in biological sciences.- Maximize your education through undergraduate research. As a biological sciences major, you’ll have numerous opportunities to conduct experiments in labs and in the field. You can work on faculty-directed research projects or apply for your own grant funding through the Office of Undergraduate Research.
- Receive instruction from experienced faculty who bring innovative teaching practices to classrooms and labs. Their specialties include ecology, evolutionary biology, cell and developmental biology, physiological ecology of plants and animals, genetics and molecular biology.
- Engage in hands-on learning opportunities in state-of-the-art facilities. Highlighted by the planetarium, the ConocoPhillips Integrated Sciences Building (CPISB) houses professional research-grade facilities and specialized labs staffed with experienced supervisors who oversee intensive studies, interactive classes, undergraduate research and special events.
- Get out of the classroom and into the field with experiential learning. Surrounded by complex ecosystems in extreme environments, the University of Alaska Anchorage offers unique opportunities to conduct field research in the polar regions and beyond.
Biological sciences bachelor’s degree program curriculum
What’s the difference between the Bachelor of Science and Bachelor of Arts degree programs in biological sciences?- With an emphasis on scientific research, the biological sciences B.S. is great for building a career in biology as a professional researcher. This program also helps undergraduate students fulfill graduate school — medicine, dentistry, veterinary science — prerequisites.
- With an emphasis on health and environmental science, the biological sciences B.A. is great preparation for careers in medical fields such as nursing, pharmacy, dentistry, wildlife management or environmental law. This program is also more flexible for students who want to double-major or minor.
Top classes for biology majors
- Design and conduct your own science experiment in Principles and Methods in Biology.
- Develop molecular and cell biology concepts in Virology and join the global response to human disease outbreaks.